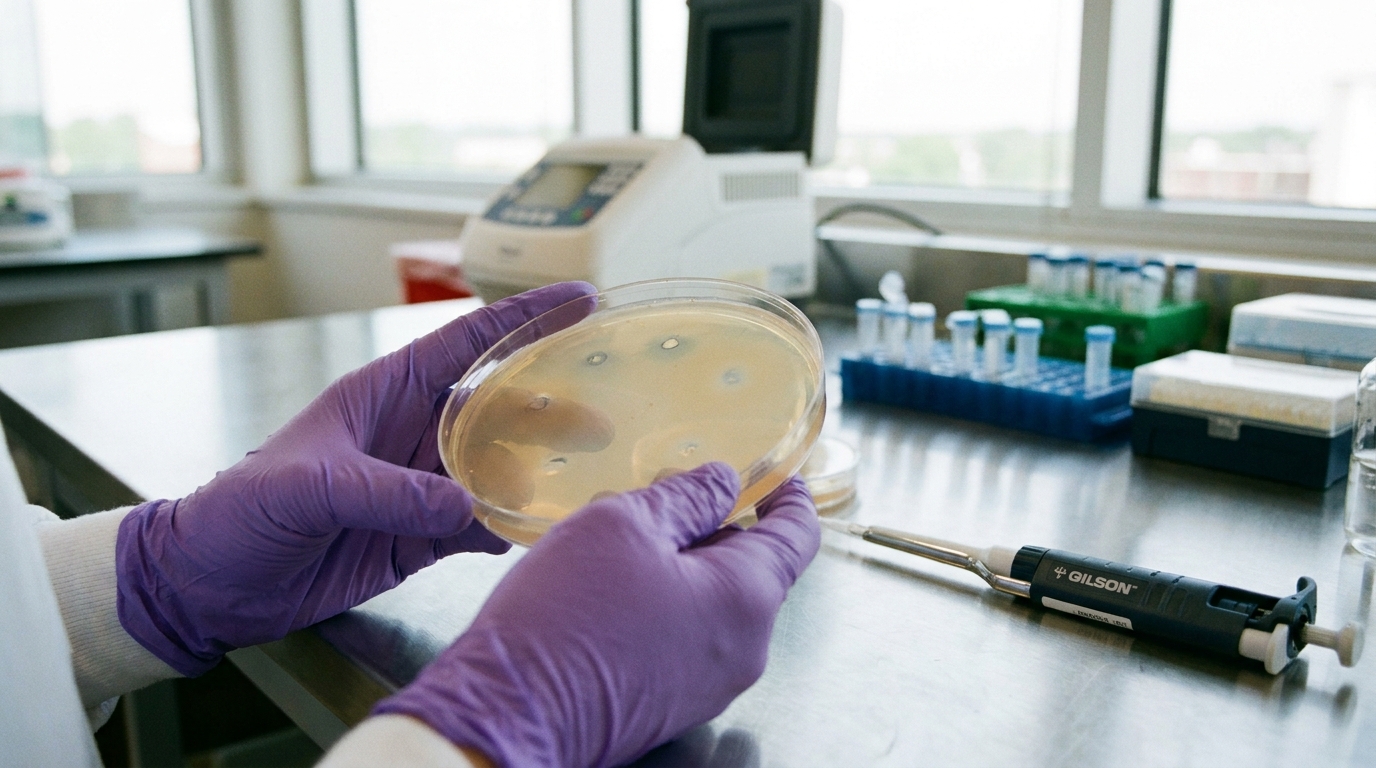
Host Antibodies and Bacterial Heteroresistance Drive Phage Therapy Failure

Host Antibodies and Bacterial Heteroresistance Drive Phage Therapy Failure
Pre-existing anti-prophage antibodies and bacterial subpopulations with reduced susceptibility may neutralize therapeutic bacteriophages.
The Clinical Lighthouse
Already a member?
or
The Clinical Lighthouse
Subscribe to read the full analysis
Full access to every article, clinical summary, and the daily evidence brief.
- Unlimited access to all articles
- Daily evidence digest
- Daily podcast with news summaries
- Lighthouse Guideline Briefings
- Ask Lumi: your guide to search, summarise, and explain the archive
- Cancel anytime
